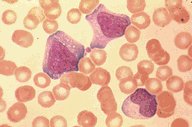

Description
Infectious mononucleosis. Reactive (or atypical)
lymphocytosis is seen in this high-oil
magnification view of the peripheral blood. These
reactive lymphocytes have pleomorphic reticular
nucleii, peripheral basophilia of cytoplasm, and
scalloped cell borders some of which appears to
stream into red cells. Slight rouleaux is also
present.
|
|
Click on this image
to enlarge it, then
on Back botton
in the Netscape Menu
to shrink it back down



|